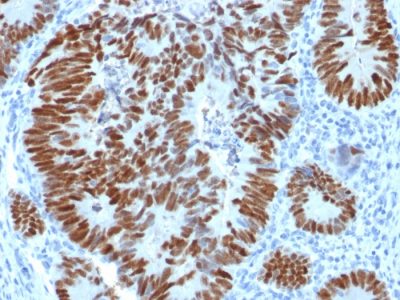

p53 Tumor Suppressor Protein Polyclonal Rabbit Antibody (N/A)
CONJUGATION
识别 53 kDa 的蛋白质,该蛋白质被鉴定为 p53 抑制基因产物。它与突变体以及野生形式的 p53 蛋白发生反应。p53 是一种在多种组织类型中表达的肿瘤抑制基因,参与调节细胞生长、复制和凋亡。它与 MDM2、SV40 T 抗原和人乳头瘤病毒 E6 蛋白结合。据报道,p53 抗体的阳性核染色是乳腺癌、肺癌、结肠直肠癌和尿路上皮癌的阴性预后因素。抗 p53 阳性也被用于区分子宫浆液性癌和子宫内膜样癌以及检测管内生殖细胞瘤。涉及 p53 的突变存在于多种恶性肿瘤中,包括乳腺癌、卵巢癌、膀胱癌、结肠癌、肺癌和黑色素瘤。
一抗可提供纯化的,或带有荧光 CF® 染料和其他标记的选择。CF® 染料具有出色的亮度和光稳定性。有关更多信息,请参阅CF® 染料手册。注意:不推荐使用 CF®405S 和 CF®405M 等蓝色荧光染料的偶联物检测低丰度目标,因为蓝色染料的荧光较低,并且比其他染料颜色可以产生更高的非特异性背景。
库存状态:由于 Biotium 提供大量抗体和偶联选择,因此可以订购一抗偶联物。CF® 染料和生物素偶联物的典型交货时间最长为 1 周,荧光蛋白和酶偶联物的交货时间最长为 2-3 周。
一抗偶联物的目录编号键
| 抗体#前缀 | 共轭 | 防爆/电磁 (nm) | 激光线 | 检测通道 | 染料特性 |
|---|---|---|---|---|---|
| BNC04 | CF®405S | 404/431 | 405 | DAPI(显微镜),AF405 | CF®405S 特点 |
| BNC88 | CF®488A | 490/515 | 488 | GFP, FITC | CF®488A 特点 |
| BNC68 | CF®568 | 562/583 | 532, 561 | RFP,TRITC | CF®568 特点 |
| BNC94 | CF®594 | 593/614 | 561 | Texas Red | CF®594 特点 |
| BNC40 | CF®640R | 642/662 | 633-640 | Cy®5 | CF®640R 特点 |
| BNC47 | CF®647 | 650/665 | 633-640 | Cy®5 | CF®647 特点 |
| BNCB | 生物素 | 不适用 | 不适用 | 不适用 | |
| BNUB | 净化的 | 不适用 | 不适用 | 不适用 | |
| BNUM | 纯化, 不含 BSA | 不适用 | 不适用 | 不适用 |
Alexa Fluor、Pacific Blue、Pacific Orange 和 Texas Red 是 Thermo Fisher Scientific 的商标或注册商标;Cy 是 GE Healthcare 的注册商标;IRDye、LI-COR 和 Odyssey 是 LI-COR Bioscience 的注册商标。
产品推荐
TrueBlack® Lipofuscin Autofluorescence Quencher
产品编号:
23007
详细视图
Paraformaldehyde, 4% in PBS, Ready-to-Use Fixative
产品编号:
22023
详细视图
EverBrite™ Mounting Medium
产品编号:
23002
- 23001
详细视图
CoverGrip™ Coverslip Sealant
产品编号:
23005
- 23005-1
详细视图
RedDot™2 Far-Red Nuclear Stain, 200X in DMSO
产品编号:
40061-T
- 40061-1
查看全部
详细视图
AntiFix™ Universal Antigen Retrieval Buffer, 10X
产品编号:
22030-50mL
- 22030-500mL
详细视图